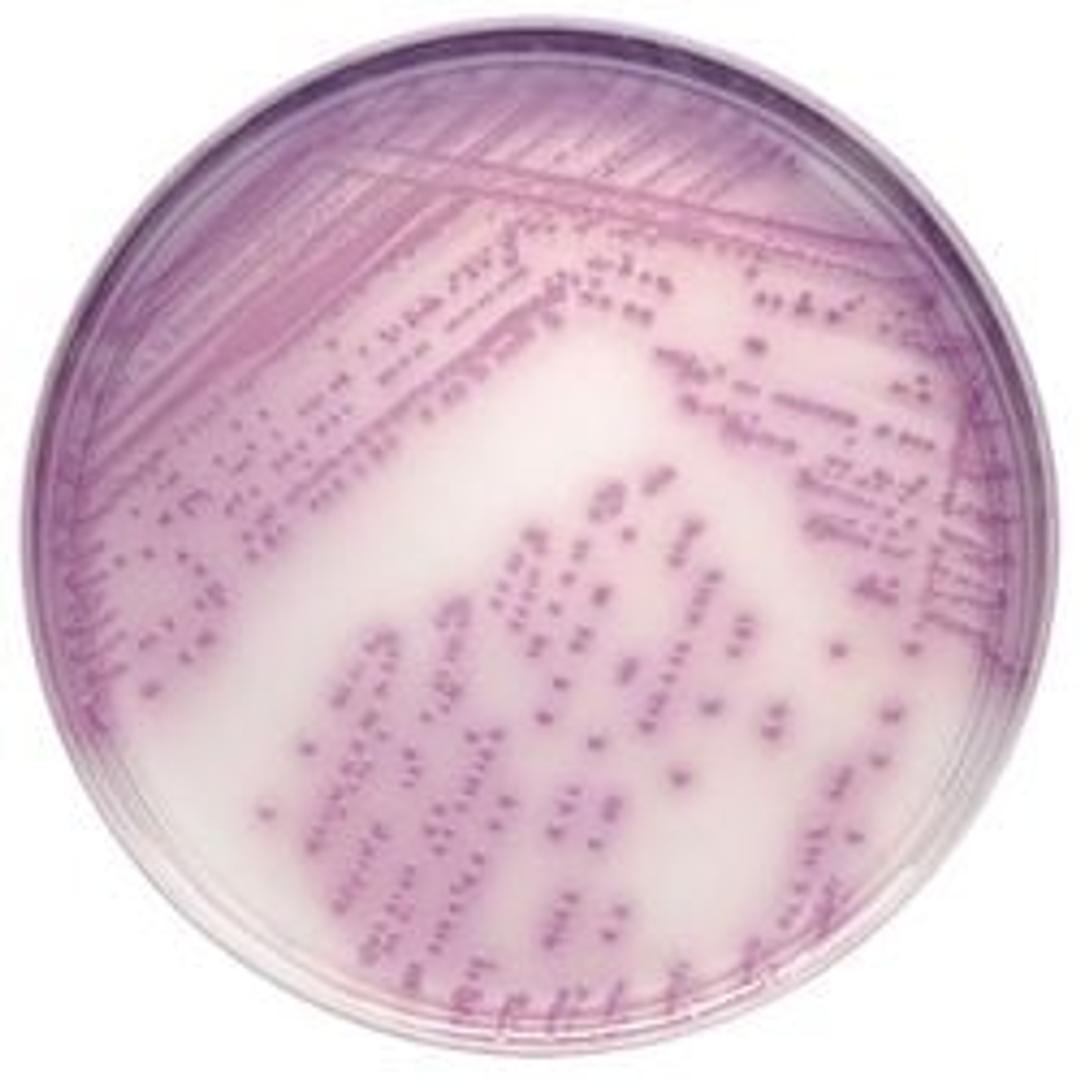
BD BBL™ CHROMagar™ Salmonella Plate

BD BBL™ CHROMagar™ Salmonella Plate
A selective and differential medium for the isolation and presumptive identification of Salmonella species from stool with a highly specific chromogenic reaction.

The supplier does not provide quotations for this product through SelectScience. You can search for similar products in our Product Directory.
BD BBL™ CHROMagar™ Salmonella
• 99% sensitivity and 97% specificity (when subculturing from Selenite F broth.)
• Differentiates low levels of Salmonella in cultures containing mixed coliform bacteria, which helps to streamline detection of pathogenic organisms.
• Salmonella detection not based on H2S or glucuronidase production, or on negative lactose fermentation, thus minimizing interference from hydrogen sulfide (H2S)-producing colonies such as Proteus and Citrobacter spp. This results in a significant reduction of false positives.
• Allows for slide agglutination and serotyping directly from the plate for more efficient use of technologists’ time.
• Reduces consumable costs associated with biochemical identification and agglutination testing of false-positive isolates.
Note: Not all products are available in all geographies, please contact your local BD representative for product details, specs, or ordering information.